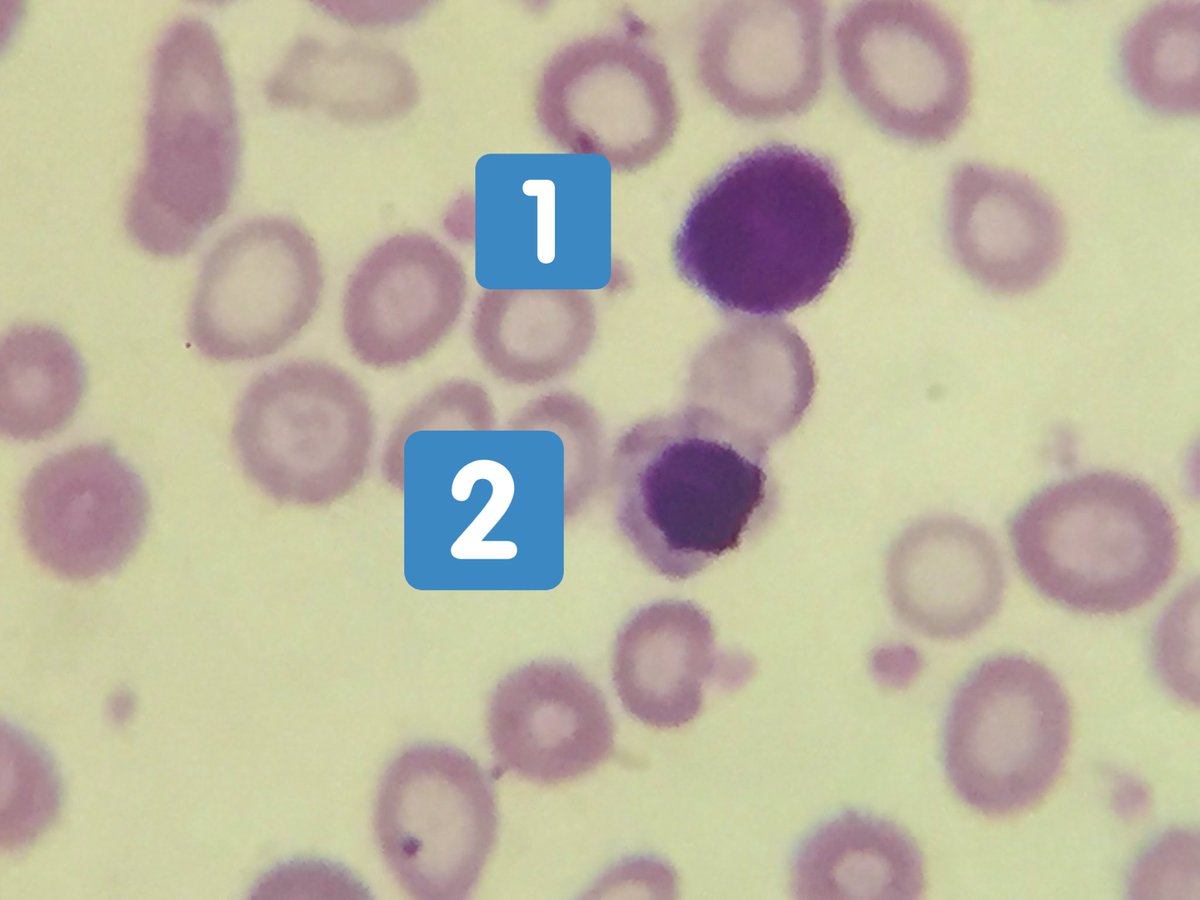

داخل الشغل في أمان الله
اول حالة طفل سنة ونص يا دكتور ومتحول عشان شاكين في سرطان في الدم كرات الدم البيضا ٤٢ الف
والخلايا الليمفاوية هي المتصدرة للمشهد
وأنيميا على ٥ Hgb
والصفائح الدموية واقعة
كل ده يتماشى مع تشخيص نوع من انواع سرطان الدم الليمفاوي ALL
قلتلهم هاتوا الولد تاني 👇🏻
اول حالة طفل سنة ونص يا دكتور ومتحول عشان شاكين في سرطان في الدم كرات الدم البيضا ٤٢ الف
والخلايا الليمفاوية هي المتصدرة للمشهد
وأنيميا على ٥ Hgb
والصفائح الدموية واقعة
كل ده يتماشى مع تشخيص نوع من انواع سرطان الدم الليمفاوي ALL
قلتلهم هاتوا الولد تاني 👇🏻
انا اللي هسحبله
سحبت واشتغلت لقيت الجهاز مدي correction يعني تصحيح ع عدد خلايا الدم
دي اول رسالة خاطئة لازم تراجعها مانيوال وتبص ع الخلايا بعيونك الجميلة ومتعتمدش ع الجهاز
عملت فيلم الدم بصيت ع الخلايا لقيت نوع من انواع خلايا الدم الحمراء الغير ناضجة بيشتبه ع الجهاز انها👇🏻
سحبت واشتغلت لقيت الجهاز مدي correction يعني تصحيح ع عدد خلايا الدم
دي اول رسالة خاطئة لازم تراجعها مانيوال وتبص ع الخلايا بعيونك الجميلة ومتعتمدش ع الجهاز
عملت فيلم الدم بصيت ع الخلايا لقيت نوع من انواع خلايا الدم الحمراء الغير ناضجة بيشتبه ع الجهاز انها👇🏻
خلايا دم بيضا normoblast وغالب اجهزة صورة الدم الصغيرة والغير حديثة بتشتبه عليها وتعدها مع كرات الدم البيضا فتعطي زيادة كاذبة في العدد
دي اول خطوة استبعدنا بيها السرطان
تاني حاجة لقيت في زيادة كبيرة في عدد الصفائح الدموية مش نقص زي ما قالوا ودي حاجة مطمئنة ان ده infection او 👇🏻
دي اول خطوة استبعدنا بيها السرطان
تاني حاجة لقيت في زيادة كبيرة في عدد الصفائح الدموية مش نقص زي ما قالوا ودي حاجة مطمئنة ان ده infection او 👇🏻
زيادة ف الصفايح الدموية حالة مشهورة مع الأنيميا الحادة خصوصا ان الولد داخل بأنيميا حادة ٥
ده تاني خطوة
انهم غالبا سحبوا العينة بالخطأ وحصل نقص خاطئ في عدد الصفايح
تم عمل مجموعة تحاليل الحديد وتم تشخيص الولد انه أنيميا نقص حديد حادة مع وجود مصدر للعدوى
ونفي موضوع السرطان بفضل الله
ده تاني خطوة
انهم غالبا سحبوا العينة بالخطأ وحصل نقص خاطئ في عدد الصفايح
تم عمل مجموعة تحاليل الحديد وتم تشخيص الولد انه أنيميا نقص حديد حادة مع وجود مصدر للعدوى
ونفي موضوع السرطان بفضل الله
الخطأ هنا خطأان
الاول preanalytical
ما قبل التحليل وهو سحب العينة
اتسحبت خطأ حصل نقص في الصفايح بالخطأ وهي زيادة
الثاني analytical في التحليل نفسه والاعتماد ع الجهاز بلايند وعدم كفاءة الأخصائي في تصحيح النتيجة وإعادتها يدويا
حاجة ممكن تفكرها بسيطة لكنها قلبت التشخيص رأسا ع عقب
الاول preanalytical
ما قبل التحليل وهو سحب العينة
اتسحبت خطأ حصل نقص في الصفايح بالخطأ وهي زيادة
الثاني analytical في التحليل نفسه والاعتماد ع الجهاز بلايند وعدم كفاءة الأخصائي في تصحيح النتيجة وإعادتها يدويا
حاجة ممكن تفكرها بسيطة لكنها قلبت التشخيص رأسا ع عقب
جاري تحميل الاقتراحات...